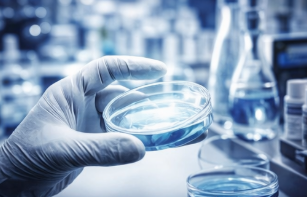

글로벌 제약·바이오산업 성장과 함께 개량신약 및 바이오시밀러 분야에서 경쟁력을 갖춘 삼천당제약이 시장의 주목을 받고 있습니다. 이번 글에서는 최근 주가 흐름과 삼천당제약 배당금 지급일 배당락일 배당 정책, 사업 구조를 정리해 보겠습니다.

삼천당제약 최근 3년 주가 흐름
최근 3년간 삼천당제약의 주가는 2023년 비교적 안정적인 흐름 속에서 점진적인 상승세를 보였습니다. 기존 의약품 사업 기반을 바탕으로 안정적인 실적을 유지하며 시장 내 입지를 유지했습니다.

이후 2024년부터는 바이오시밀러 및 글로벌 진출 기대감이 반영되며 주가가 상승 흐름을 이어갔습니다. 2025년에는 해외 파트너십 확대와 신약 개발 기대감이 부각되며 상승폭이 확대되었고, 2026년 3월에는 1,195,000원을 기록하며 3년 기준 최고가를 형성했습니다. 현재는 단기 급등 이후 고점 부근에서 변동성이 확대된 상태입니다.
삼천당제약 배당금 지급일 배당락일
삼천당제약은 회사 이익의 일정 부분을 주주에게 환원하는 배당 정책을 유지하고 있으며, 사업 계획과 투자 필요성, 재무 안정성 등을 종합적으로 고려하여 배당 규모를 결정하고 있습니다.

또한 미래 성장과 주주환원을 균형 있게 고려하는 전략을 기반으로 지속적인 배당 정책을 이어갈 계획입니다. 위의 표를 통해 최근 지급된 삼천당제약 배당금 지급일 배당락일 정보를 확인하시기 바랍니다.
삼천당제약 기업 소개
삼천당제약은 안과질환 치료제와 바이오시밀러를 중심으로 글로벌 시장 진출을 추진하는 연구개발 중심 제약기업입니다.
전문의약품 사업 부문
삼천당제약은 안과용 의약품을 중심으로 다양한 전문의약품을 개발 및 생산하고 있습니다. 점안제 기술을 기반으로 차별화된 제품을 공급하며 국내 시장에서 안정적인 매출을 확보하고 있습니다. 지속적인 품질 개선과 생산 효율화를 통해 경쟁력을 유지하고 있으며, 기존 제품의 개량과 신규 제품 개발을 통해 사업 포트폴리오를 확장하고 있습니다


바이오시밀러 사업 부문
바이오의약품 복제약인 바이오시밀러 개발을 통해 글로벌 시장 진출을 적극 추진하고 있습니다. 해외 제약사와의 협력을 기반으로 임상 및 허가 절차를 진행하며, 글로벌 시장에서의 상업화를 목표로 하고 있습니다. 고령화와 의료 수요 증가에 따라 바이오시밀러 시장이 확대되고 있는 만큼, 중장기 성장의 핵심 축으로 평가되고 있습니다.

글로벌·신약 개발 부문
신약 개발과 글로벌 라이선스 아웃을 통해 미래 성장동력을 확보하고 있습니다. 해외 시장을 타깃으로 한 임상 개발을 진행하며 기술수출 가능성을 높이고 있습니다. 연구개발 투자를 지속적으로 확대하며 파이프라인을 강화하고 있으며, 글로벌 제약사와의 협력을 통해 사업 확장을 추진하고 있습니다. 이러한 전략은 단순 의약품 제조를 넘어 연구개발 중심 기업으로 도약하기 위한 핵심 요소로 작용하고 있습니다.



이상으로 삼천당제약 배당금 지급일 배당락일 배당 등 다양한 기업 정보에 대해 알아보았습니다.
'배당 > 2026년 배당금' 카테고리의 다른 글
| 두산에너빌리티 배당금 지급일 배당락일 배당 정보는? (0) | 2026.04.16 |
|---|---|
| 삼성전자우 주가 배당금 지급일 배당락일 (0) | 2026.04.07 |
| SK하이닉스 배당금 지급일 배당락일 배당 정보 알아보자 (0) | 2026.03.27 |
| 삼성전자 배당금 지급일 배당락일 배당 정보 알아보자 (0) | 2026.03.27 |
| 포스코홀딩스 배당금 지급일 배당락일 / 2026년 최신정보 (1) | 2026.03.20 |